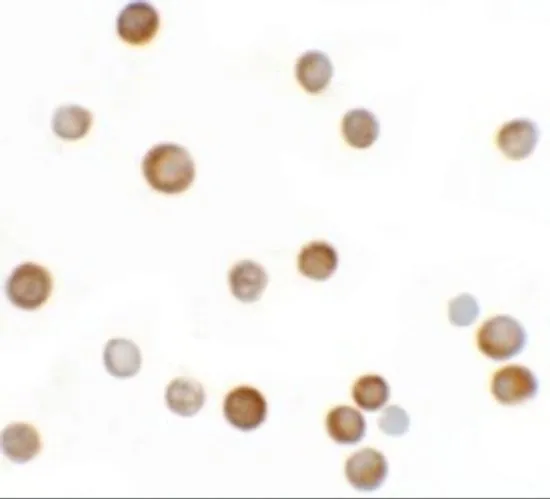

ICC/IF analysis of HeLa cells using GTX32063 YPEL2 antibody. Working concentration : 2.5 μg/ml
YPEL2 antibody
GTX32063
ApplicationsImmunoFluorescence, Western Blot, ELISA, ImmunoCytoChemistry
Product group Antibodies
ReactivityHuman, Mouse
TargetYPEL2
Overview
- SupplierGeneTex
- Product NameYPEL2 antibody
- Delivery Days Customer9
- Application Supplier NoteWB: 1 microg/mL. ICC/IF: 2.5 microg/mL. *Optimal dilutions/concentrations should be determined by the researcher.Not tested in other applications.
- ApplicationsImmunoFluorescence, Western Blot, ELISA, ImmunoCytoChemistry
- CertificationResearch Use Only
- ClonalityPolyclonal
- Concentration1 mg/ml
- ConjugateUnconjugated
- Gene ID388403
- Target nameYPEL2
- Target descriptionyippee like 2
- Target synonymsFKSG4, protein yippee-like 2, DiGeorge syndrome-related protein
- HostRabbit
- IsotypeIgG
- Protein IDQ96QA6
- Protein NameProtein yippee-like 2
- ReactivityHuman, Mouse
- Storage Instruction-20°C or -80°C,2°C to 8°C
- UNSPSC12352203



